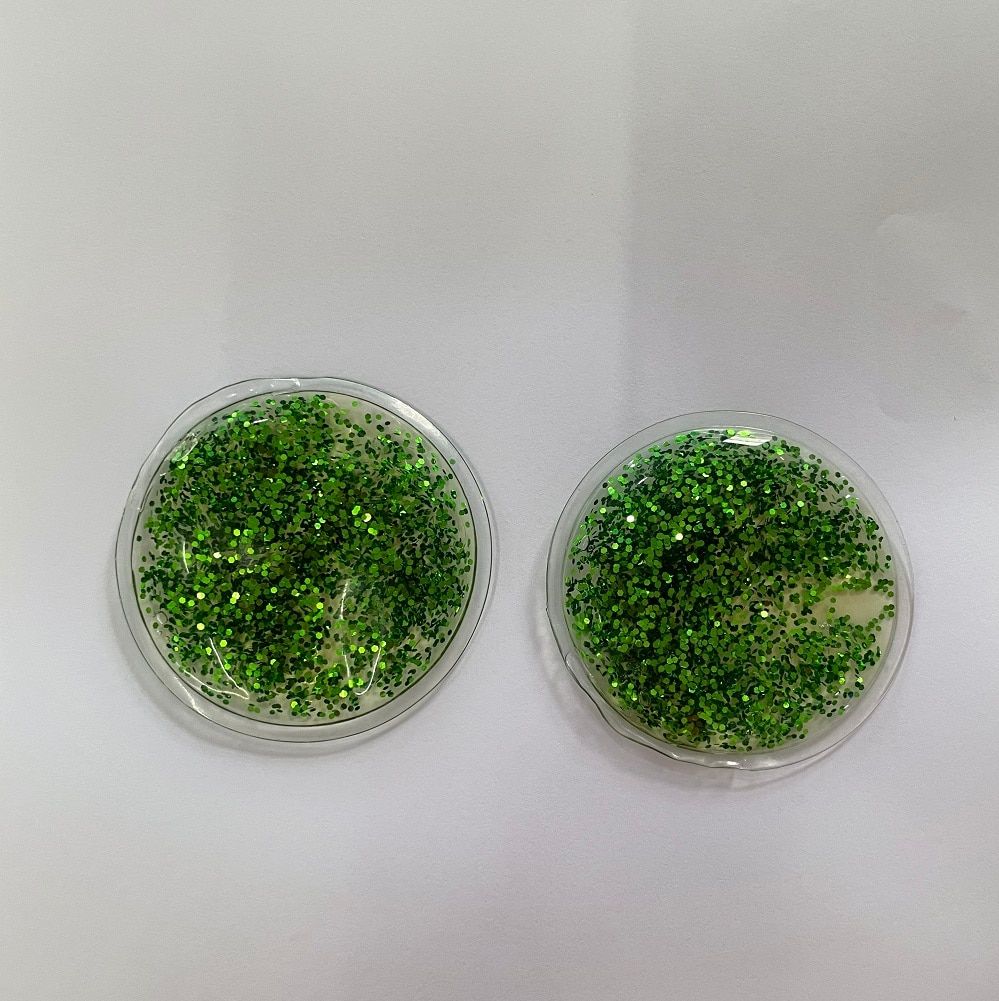

2 Шт., Многоразовые Гелевые Подушечки Для Глаз Для Снятия Симптомов Боли В Глазах
- 96 отзывов
- 211 Продано
USD $3.19НДС включен50% СКИДКАБесплатная доставка
только для дропшиппинга и оптовой продажи
Как платить ?
- Доставка в течение 24 часов с помощью быстрой доставки.
- Расчетная доставка от 5 до 9 рабочих дней.
Отзывы клиентов
*Примечание. Некоторые отзывы были обработаны Google Переводчиком!Материал: композитный материал
Применение: лицо
Тип товара: глазовый патч
Номер модели: ATP034
Dropshipping / Оптовая продажа: поддержка
Логотип настроен: да
Цвет индивидуальный: хорошо
Добро пожаловать в магазин
(● ''D' ●)
У нас лучшая цена на оптовую и прямую поставку
Пожалуйста, свяжитесь с нами, если у вас есть какие-либо вопросы